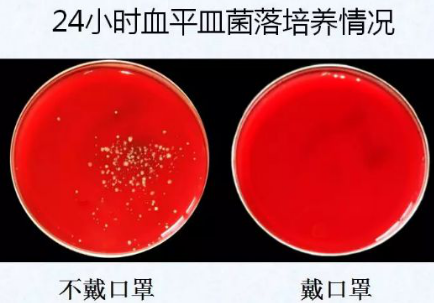
24.png

【北京疾控提醒您】预防新型冠状病毒,最重要的第三招:知礼仪
日期:2020-01-25
来源:北京市疾病预防控制中心
疾控君为您带来预防新型冠状病毒最重要的第三招:
知礼仪
预防新型冠状病毒感染的肺炎
打喷嚏咳嗽产生的飞沫能够传播细菌或病毒,进而传播疾病,即便是健康人打喷嚏和咳嗽,产生的飞沫中也可能携带细菌或病毒!

你知道打喷嚏和咳嗽
产生的飞沫能扩散多远吗?
当我们打喷嚏或咳嗽时,产生的飞沫像一团云迅速扩散,能够把细菌或病毒带到2米左右的距离。
所以为避免细菌或病毒通过飞沫传播,至少需要保持2米的距离。

已经出现咳嗽打喷嚏症状,
如何避免传播给他人?
尽量与他人保持2米以上的距离,如果在人员密集的场所(如在早高峰的地铁上),可以通过佩戴口罩避免传播给他人。

当生病时,无论是去医院就诊还是在家休息,佩戴口罩能够给您和他人安心的防护。
打喷嚏时用手捂住可以吗?
正确的做法是什么?
很多人打喷嚏时都会下意识用手捂住,但其实这是错误的!

在日常生活中,打喷嚏或咳嗽时,可以用纸巾遮掩口鼻。

如果一时情急,来不及准备,可以用肘部衣袖遮掩。

因为肘部接触其他地方的机会少,不容易造成细菌和病毒的散播。
这不仅是防止疾病传播的办法,也是文明素养的表现。
为了你我的健康,请做到:
打喷嚏,掩口鼻,
习礼仪、讲卫生。